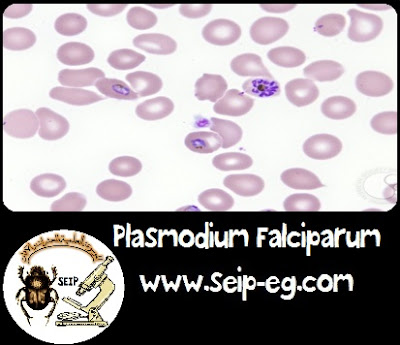

الملاريا – نظرة عامة Malaria
![]() |
| Malaria |
مرض الملاريا Malaria :
تاريخ المرض في مصر :
– توطن مرض الملاريا في مصر منذ عهد قدماء المصريين كما هو مسجل بكتب التاريخ.
– عام 1903 تم عمل أول مسح وبائي بمنطقة القناة وتبين ان 30% من الاهالي
مصابين بمرض الملاريا
– عام 1925 تم تحديد انواع البعوض الناقل لطفيل الملاريا بمصر( انثي بعوض الانوفيليس فرعوني وسيرجنتي) كعائل ناقل اساسي لطفيل الملاريا عام 1936 تم انشاء اول قسم لمكافحة الملاريا بوزارة الصحة
– عام 1942 تعرضت مصر لأول موجة من الاصابة من مرض الملاريا الخبيثة
والتي سببها طفيل البلازموديوم فالسيبارم والمنقول بواسطة بعوضة الانوفيليس
جامبيا الوافدة من السودان وذلك خلال اعمال النقل النهري للبضاعة والمسافرين
مما ادي الي حدوث الاف الوفيات بالمحافظات الجنوبية الاربعة (اسوان – قنا
سوهاج – اسيوط).
– تم الاعلان عن حملة لاستئصال بعوضة الجامبيا من مصر بالاشتراك مع منظمة الصحة العالمية حتي تم الاعلان عن استئصال بعوضة الجامبيا وخلو مصر منها عام 1946 حيث تم استخدام مبيد ال د.د.ت عن طريق الرش بالطائرات .
* في 4 يناير 1946 تم الاعلان عن استئصال بعوضة الجامبيا نهائيا من مصر
– وصلت نسب الاصابة في بعض المحافظات الي اكثر من 20% وذلك عام 1960
– استمرت اعمال الترصد الحشري جنبا الي جنب مع اعمال الترصد الوبائي لمرض الملاريا وذلك من خلال اعمال الاستقصاء
المباشر والغير مباشر مع متابعة حالات الحمي وصرف العلاج الافتراضي لجميع
الحالات ومعالجة جميع الحالات الايجابية للملاريا علاجا قاطع مما كان له اكبر
الاثر في بدء انحسار مرض الملاريا عن معظم المحافظات عام 1990.
– وقد تمت هذه الاعمال من خلال وحدات الملاريا التي تم انشاؤها بمعظم مراكز محافظات الجمهورية.
دورة الحياة طفيل الملاريا:
اولا : داخل البعوضة (دورة الحياة الجنسية او الاساسية-Sexual life cycle ) :
– عندما تقوم انثي بعوضة الانوفيليس – المعروفة بنقلها لطفيل الملاريا- بلدغ انسان مصاب بالمرض او حامل الاطوار الجنسية (للجاميتوسيتات) فانها تمتص من دمه حوالي 50 ميكرون وتقوم المعدة بهضم جميع الاطوار عدا الاطوار الجنسية التي تنمو وتتطور داخل تجويف معدة البعوضة حيث يخرج من الجاميتوسايت المذكرعدد ( 6-8 ) بروزات كالاهداب تنفصل عن جسم الجاميتوسايت وتسبح في تجويف المعدة ويسمي كل منها (Microgamete) اما الجاميتوسايت الانثوي فانه يبلغ ويسمي (Macrogamete) وتبدأ عملية الاخصاب عندما يخترق الميكروجاميت الخيطي الماكروجاميت المكور المكورة وتتحد النواتان وينتج عن هذا الاتحاد البويضة الملقحة او المخصبة المعروفة بإسم (الزيجوت) الذي يتطور ويتحول الي طور أميبي ( الأؤوكنيت – Ookinte ) الذي يتحرك حركة لولبية في تجويف المعدة حيث يثقب جدار المعدة ويستقر بين جدار المعدة والغشاء المحيط بها حيث يعرف باسم البويضة المتكيسة (الأؤوسيست- Oocyst)و تبدأ النواة في النمو والإنقسام العادى حتي يتكون ما يقرب من 10000 نوية وتقوم كل نوية بتغليف نفسها بقطعة من السيتوبلازم وتصبح مغزلية الشكل ويعرف باسم السبوروزويتات ( Sporozoite ) ويعرف هذا الطور بإسم السبوروزويتات المتكيسة ( Sporocyst) حيث ينفجر الكيس وتخرج السبوروزويتات وتسبح في سائل تجويف جسم البعوضة Haemocele) ) وتتجه السبوروزويتات (الطور المعدى Infective Stage ) الي الغدد اللعابية الموجودة في صدر البعوضة -وتصبح البعوضة معدية- تبقي السبوروزويتات مع اللعاب وتخرج معه اثناء قيام البعوضة بلدغ إنسان سليم للحصول منه على وجبة الدم التالية حيث تبدأ الإصابة بالمرض .
– (تتم هذه الدورة داخل جسم البعوضة فى فترة تتراوح بين 10-15 يوم وتتوقف على درجة الحراة والرطوبة النسبية بمناطق التوطن).
ثانيا: دورة حياة الطفيل داخل الانسان(الدورة اللاجنسية او النسيجية- Asexual Tissue cycle
1- الدورة الكبدية في الانسان- (الدورة النسيجية Tissue cycle-) او( الدورة الأولى خارج كرات الدم الحمراء Primary Exo–erythrocytic Schizogony))
عندما تقوم البعوضة المعدية بلدغ انسان آخر فانها تنفث بعض اللعاب الملوث بالسبوروزويتات في الجرح الذي تحدثه بالجلد ، ويسبب لعاب البعوضة احتقان دموي في منطقة اللدغ ،كما أنه يحتوى على موانع لتجلط الدم حتى تتمكن البعوضة من اخذ وجبتها، وتسبح السبوروزويتات مع اللعاب في دم الانسان حيث تخترق خلايا الكبد(Parynchymal liver cells) وتختفي من الدم في خلال نصف الساعة ، وفي خلايا الكبد تتكور السبورزويتات وتنمو وتنقسم النواة عدة مرات حتي يصل عددها ما بين 800 الي 40 الف نوية (علي حسب نوع الطفيل واكثرها في البلازموديوم فالسيبارم واقلها في البلازموديوم مالاري ) ، وتتطور السبوروزويتات في نفس الخلايا المصابة اليوتتحول إلى الطور المتغذىوالمعروف بإسم تروفوزويت ( Trophozoite) , وينضج هذا الطور ويبدأ فى الإنقسام ويسمى بالطور الإنقسامى ( Schizont) ويتنهي بانفجار خلية الكبد المصابة وخروج الميروزويتات الكبدية (Hepatic Merozoites) بأعداد كبيرة حيث يعيد معظمهاالهجوم على خلايا الكبد مرة أخرى ويحدث ما يسمى بالدورة النسيجية الثانوية :Secondary exo erhtrocytic Schizogony فى انواع البلازموديوم فايفاكس،اوفالى والملاري وتكمن فى خلايا الكبد حيث تظهر بعد فترات من العلاج الغير قاطع وتسبب ما يعف بإسم الملاريا الإنتكاسية (Relapses) وباقى الميروزويتات تقوم بمهاجمة كرات الدم الحمراء بالنسيج الدموى ، أما فى حالة البلازموديوم فالسيبارم فإن جميع الميروزويتات الكبدية تقوم بمهاجمة كرات الدم الحمراء ولا تعيد الهجوم على خلايا الكبد.
الدورة النسيجية الثانوية :Secondary exo erhtrocytic cycle
الدورة الدموية اللاجنسية :) Asexual -Erythrocytic Schizogony)
الدورة الدموية الجاميتية (Gamytogony ) :
مصدر العدوي بالملاريا:
الصورة الاكلينيكية للمرض :
أعراض مرض الملاريا:
مضاعفات الملاريا :
فقر الدم والانيميا: تقل عدد كرات الدم الحمراء نتيجة اصابتها بالطفيل وانفجاره وبالتالي تقل نسبة الهيموجلوبين في الدم فينتج فقر دم وهذال شديد
تضخم الطحال Splenomegaly حيث ان الطحال هو العضو المسئول عن تعويض كرات الدم الحمراء المفقودة بالاضافة الي التخلص من كرات الدم الحمراء المصابة مما يؤدي الي زيادة الجهد الواقع عليه فيتضخم وقد ينفجر لأقل صدمة خفيفة
تضخم الكبد: ينتج عن انفجار كرات الدم الحمراء مادة الهيموجلوبين الذي يتكسر الي الهيماتين والجلوبين ويضطر الكبد الي التخلص منها فضلا عن اصابة الخلايا الكبدية بالطفيل في الدورات الكبدية وينتج عن ذلك كسل في الكبد قد يؤدي الي التضخم والفشل في وظيفته
حمي البول الأسود: في حالة الاصابة بالملاريا الخبيثة فان مادة الميتاهيموجلوبين تترسب في خلايا الكلي وتخرج عن طريق البول وتسمي حمي البول الاسود
ملاريا الجهاز العصبي ( Cerebral Malaria ): تكتسب كرات الدم الحمراء في حالة الملاريا الخبيثة خاصية الالتصاق ببعضها وفي جدران الاوعية الدموية مما ينتج عنه انسداد في هذه الاوعية وحدوث مضاعفات تشبه الحمي المخية الشوكية وقد ترتفع درجة الحرارة ارتفاعا شديدا وتؤثر في مركز تنظيم الحرارة بالمخ
اجهاض المرأة الحامل : ينتقل الطفيل من الأم إلى الجنين عن طريق المشيمة وحدوث موت الجنين.
تسبب الاعاقة في نمو الاطفال المصابين .
1- أعراض الملاريا الخبيثة الحادة في المناطق الاستوائية وتحت الاستوائية :
) مدة حضانة المرض من 9-12 يوم )
· صداع وهو عرض اساسي هام وعادة ما يكون مستمر وشديد ويصاحبه اعياء وقيء واضطراب ذهني
· الرعشة:تكون بسيطة وقصيرة ويتبعها مرحلة من السخونة الطويلة
· الارتفاع في درجة الحرارة وهي عبارة عن حمي مستمرة وليست متقطعة ولا توجد فترة محددة تكون فيها درجة الحرارة طبيعية وفي بعض الاحيان تكون الحمي منخفضة ولا يبدو علي المريض اي اعراض ولكن يصاحبها عرق وربما تزيد نوبة حدوث الغثيان والقيء والاسهال وهناك علاقة طردية بين شدة المرض وعدد الطفيل في الدم Parasitic count والمضاعفات
· العرق : ويكون اقل شدة عن باقية الانواع الاخري
الأنواع الاكلينيكية للملاريا الخبيثة
1- ملاريا الجهاز العصبي – Cerebral malaria :
2-ملاريا شديدة الحمي – Hyperpyrexia:
3- الملاريا الباردة– :Algid
4- ملاريا الجهاز الهضمي : Gastrointestinal malaria
· شبيهة الكوليرا: Cholerytic malaria تتميز باسهال شديد وغزير مع حدوث تقلصات في الاطراف والبطن مع قيء وغثيان ويكون البراز به مخاط ودم علي عكس الكوليرا مع وجود كثافة للطفيل بجميع اطواره في الدم الطرفي.
· شبيه الدوسنتاريا : Dysentric malaria يماثل بشدة الدوسنتاريا ويصعب تفريقه الا بتحليل الدم او البراز
· شبيه بالمرارية : Bilous type وغالبا ما يكون مصحوب بتلف في خلايا الكبد وتضخم والم واصفرار العينين وغالبا ما يظهر من البداية ويتطور بمرور الوقت ويصاحبه غثيان وقيء، ويكون القيء مصحوبا بالعصارة المرارية
طرق التشخيص المعملى للملاريا :
1- التشخيص المباشر:
نظراً لأن الإصابة بطفيل الملاريا تكون عادة مصحوبة بإرتفاع فى درجات الحرارة مثل العديد من الأمراض الباكتيرية والفيروسية لذا فإنه من الصعب التفرقة بينها وبين هذه الإصابات .
وللتأكد من إصابة المريض بطفيل الملاريا يجب فحص عينة دم للمريض للتحقق من وجود الأطوار المختلفة للطفيل بما يؤكد الإصابة بالمرض.
يتم جمع عينة دم للمريض بطريقة المسحة السميكة أو الرقيقة بعد صبغها بصبغة جيمسا (يفضل فحص العينة السميكة لإمكان إحتوائها على كمية أكبر من طبقات الدم (20-40 طبقة ) .
من المهم دقة التمييز بين الطفيل وباقى محتويات الدم مثل الصفائح الدموية والشوائب العالقة.
2- التشخيص الغير مباشر( التشخيص السيرولوجى):
منذ بداية الستينيات وجدت العديد من الطرق التى إعتمدت على التحقيق من وجود الأجسام المضادة للطفيل بسائل الدم (المصل) وهو ما يعرف بالتشخيص المصلى أو السيرولوجى ومن هذه الطرق:
– الفحص المناعى الوميضى ( Immuno Fluorescence)
– التجلط المناعى الدموى الغير مباشر ( Indirect Haemoagglutination)
وهذه الطرق تفيد فى أعمال المسح الأولى الشامل ولكن لايمكن الإعتماد كلية عليها لأنها:
– يمكن أن تحدد الإصابة بمرض الملاريا ولكنها لايمكن التحقق من نوع الطفيل المسبب وهو ما يتوقف عليه تحديد العلاج الواجب صرفه للمريض .
– الإرتفاع الغير عادى فى التكلفة مقارنة للتكلفة الفعلية للفحص بالطرق المباشرة .